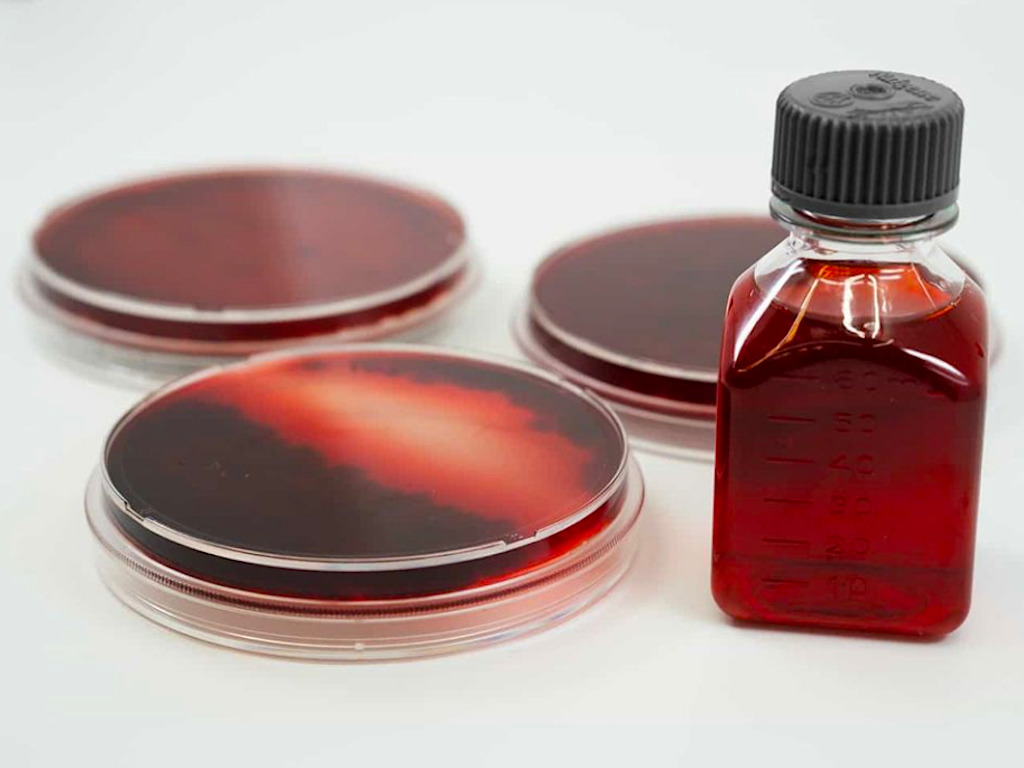

3 Mins Read Michroma is developing natural vegan-friendly food colourants powered by fungi to overhaul synthetic and animal-based, non-vegan food dyes. The food colourant market is dominated by synthetics and animal-derived products, but startups are now rising to the challenge with animal-free and natural solutions. One of them is Michroma, a synbio firm that says it has developed […]
The post This Startup Is Taking Down Synthetic Food Dyes with Fungi-Powered Colourants appeared first on Green Queen.
This post was originally published on Green Queen.